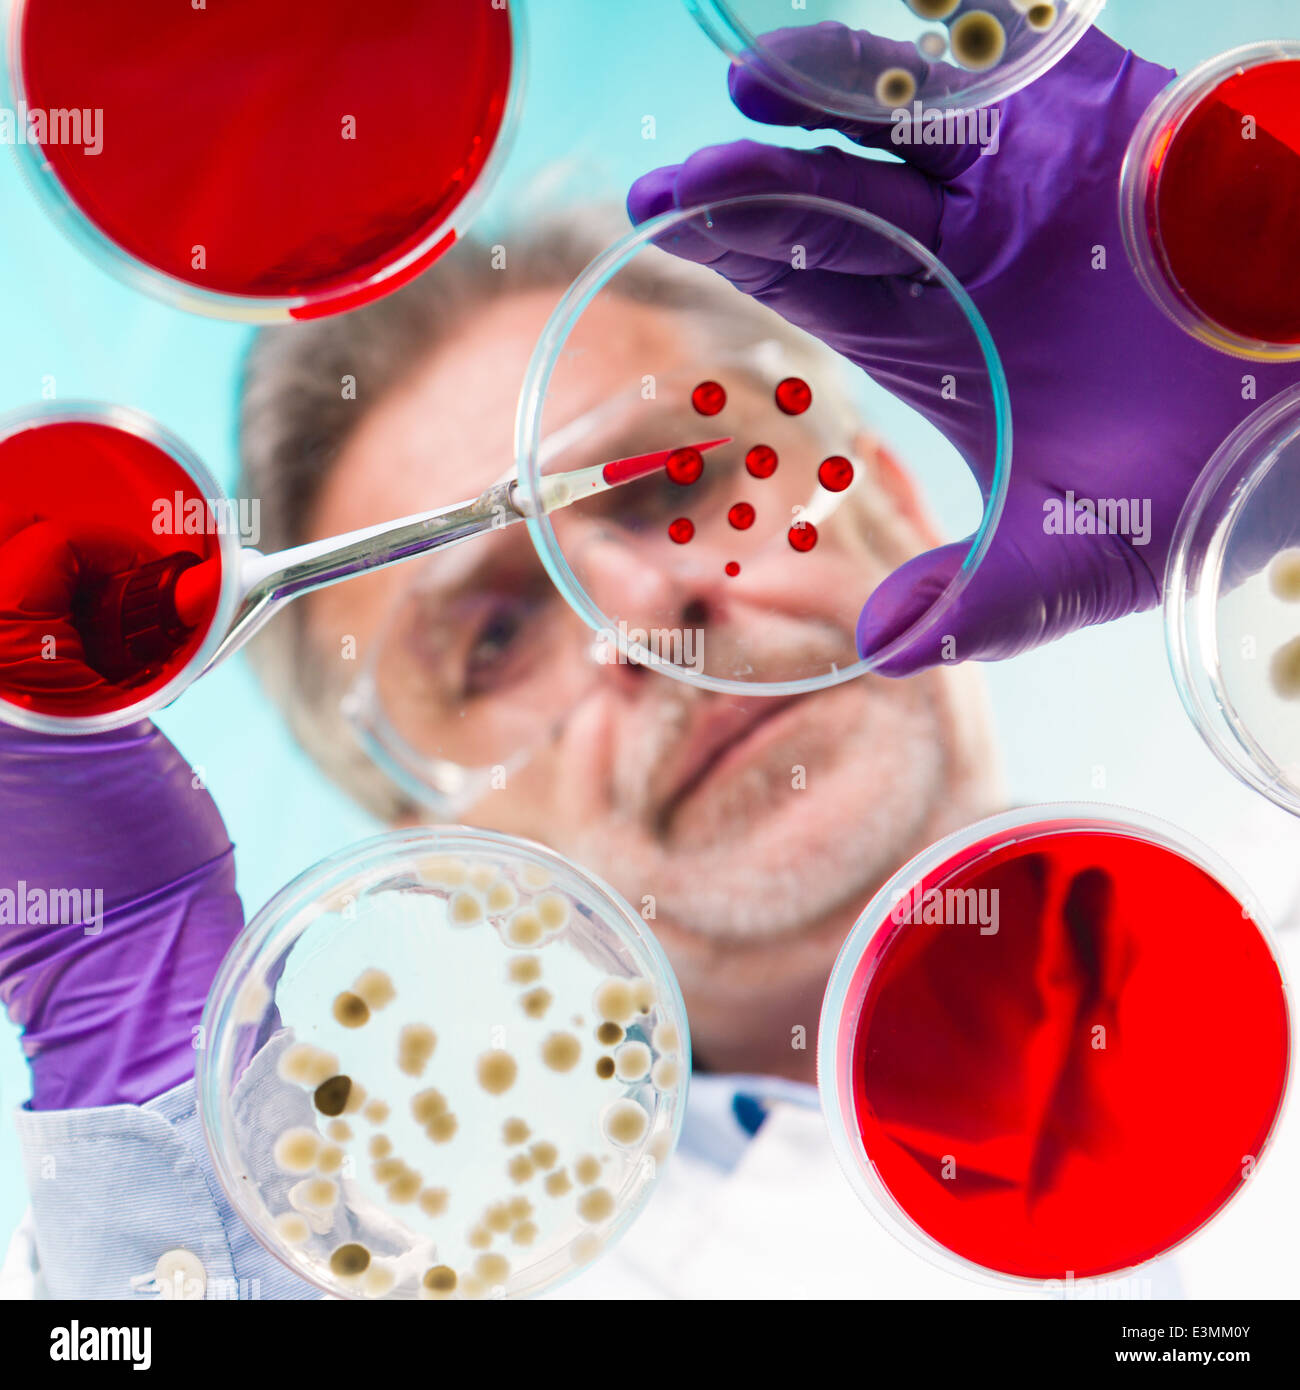
Senior Life-Science-Forscher Pfropfung Bakterien. Stockfoto

Schnellfilter:
Life science Stockfotos & Bilder

RMM26NHT–Wissenschaftler verwendet Fluoreszenzmikroskop Ausrüstung heraus eine quantitative Assay eines biochemischen Experiment durchzuführen.

RFPNBFGR–Abstraktes Bild von organischen Sphären im Konzept der Herkunft und die Vermehrung des Lebens.

RF2BR4PAT–Fokussierte Senior Life Science professionelle Pfropfen Bakterien in den Pettri-Schalen. Objektivfokus auf der Pipette. Schwarzweiß-Bild.

RFB11RC9–Plasma-Ball. Plasmalampen gibt es in Kugeln und Zylinder. Plasma-Lampe ist in der Regel eine Klarglas-Kugel.

RM2H04XA7–Das Zentrum für zahnärztliche und biowissenschaftliche Forschung Witten (ZBZ), Witten, Nordrhein-Westfalen, Deutschland. Zahnmedizinisch-Biowissenschaftliches Forschung

RF3B17KJA–CAMBRIDGE, MASSACHUSETTS - 1. April 2025: Alexandria Center am One Kendall Square, Megacampus mit verschiedenen Life-Science-Unternehmen, führenden Universitäten,

RMPCRNAE–Luftaufnahme, Fakultät für Zahnheilkunde - Life Science Research Center FEZ II, Institut für Umwelttechnik und Management an der Universität Witten Herdecke GmbH, der zahnmedizinischen Klinik der Universität Witten Herdecke, FEZ, Witten, Ruhrgebiet, Nordrhein-Westfalen, Deutschland, Europa

RM3BN0KX9–Schild des Life Science Center in Keilaranta 10-18 im Bezirk Keilaniemi in Espoo, Finnland

RMGG73AN–Ausstellung auf dem Monte L. Bean Life Science Museum auf dem Campus der Brigham Young University in Provo, Utah.

RF2JA9R89–Riesiges Werbeschild für die Weltraumzone im Life Science Center, Newcastle upon Tyne, Großbritannien.

RM2H04XA8–Das Zentrum für zahnärztliche und biowissenschaftliche Forschung Witten (ZBZ), Witten, Nordrhein-Westfalen, Deutschland. Zahnmedizinisch-Biowissenschaftliches Forschung

RFHJCKCF–Das Millipore Sigma Zeichen, Life-Sciences-Tochtergesellschaft von Merck, außerhalb einer Lage in Milwaukee, Wisconsin.

RM2F3DF95–Luftaufnahme von Newcastle upon Tyne mit dem Bahnhof, Life Science Center und Newcastle College alle prominent

RF2G76T50–Ein Rover auf der marsoberfläche auf der Suche nach Lebenszeichen. 3D-Illustration für Wissenschaft und Forschung.

RF2CD0GF7–Leben auf dem alten Mars, flüssiges Wasser und blühende Lebensformen in der frühen Marslandschaft

RFHWEM2X–Life Science, Wissenschaftler halten eine Probe in ein Eppendorf-Fläschchen während eines Experiments im Labor

RM3BN0KX6–Bürokomplex des Life Science Center in Keilaranta 10-18 im Bezirk Keilaniemi in Espoo, Finnland

RFGCYRJ4–Junge asiatische Wissenschaftler im Bereich Life Science im Labor mit Handschuhen pipettieren

RMGG73AT–Ausstellung auf dem Monte L. Bean Life Science Museum auf dem Campus der Brigham Young University in Provo, Utah.

RM3BJP2EA–Die Bio-Techne Corporation ist ein amerikanisches Life-Sciences-Unternehmen, das biowissenschaftliche Reagenzien, Instrumente und Dienstleistungen für entwickelt, herstellt und vertreibt

RF2KAYTGF–Außenansicht des Gebäudes des Life Science Center, einer Besucherattraktion in der Stadt in Newcastle upon Tyne, Großbritannien.

RM2H04XAK–Das Zentrum für zahnärztliche und biowissenschaftliche Forschung Witten (ZBZ), Witten, Nordrhein-Westfalen, Deutschland. Zahnmedizinisch-Biowissenschaftliches Forschung

RFHJCKCJ–Das Millipore Sigma Zeichen, Life-Sciences-Tochtergesellschaft von Merck, außerhalb einer Lage in Milwaukee, Wisconsin.

RM3B3FH6P–Luftaufnahme des Life Science Centre im Stadtzentrum von Newcastle upon Tyne. (Auch Leonardo Hotel Newcastle in Foregound)

RF3BR73J3–Das kreisförmige Life-Science-Gebäude Forskaren in Hagastaden in Stockholm, Schweden. Es wurde als Best Office Building 2024 und Stockholm Building of the ausgezeichnet

RFHWEM34–Life Science, Wissenschaftler halten eine Probe in ein Eppendorf-Fläschchen während eines Experiments im Labor

RMGG73AK–Ausstellung auf dem Monte L. Bean Life Science Museum auf dem Campus der Brigham Young University in Provo, Utah.

RM2S0TJKA–UK University of Bradford University UK Norcroft Building Institute of Life Science Research Bradford Yorkshire England UK GB Europa

RF2JA9R8M–Rückansicht des Life Science Center, Newcastle upon Tyne, Großbritannien, mit farbenfrohen Designelementen unter einem blauen Himmel.

RF3BR70DG–Das kreisförmige Life-Science-Gebäude Forskaren in Hagastaden in Stockholm, Schweden. Es wurde als Best Office Building 2024 und Stockholm Building of the ausgezeichnet

RFT8MENN–Brillen auf ein offenes Buch mit Protozoen Medizinische Parasitologie im Fokus mit anderen Life Science text Bücher im Hintergrund unscharf

RFHWEM31–Life Science, Fläschchen Pipettieren eine Probe in ein Eppendorf Wissenschaftler während eines Experiments im Labor

RMPBAEYB–Foto der Charles Darwin durch Sperren & Whitfield 1877 übernommen und in "Männer von Mark" 1878 veröffentlicht.

RFGCYREW–junge asiatische Wissenschaftler Pipettieren im Life-Science-Labor auf der Suche nach Heilung

RMGG73AY–Ausstellung auf dem Monte L. Bean Life Science Museum auf dem Campus der Brigham Young University in Provo, Utah.

RMBB1GKX–Fünfte Klasse Studenten Schüler studieren Ökologie eines Baches im Montgomery County, Bundesstaat New York

RF2KAYTN8–Außenansicht des Gebäudes des Life Science Center, einer Besucherattraktion in der Stadt in Newcastle upon Tyne, Großbritannien.

RMD6GCPY–Das Konferenzzentrum im Zentrum des Lebens. Ein Zentrum für Welt-Klasse-Wissenschaft in Newcastle Upon Tyne.

RM2B9YABD–Konzept eines Gesundheitsforschers, eines Forschers, der in einem Life-Science-Labor arbeitet, eines jungen Forschungswissenschaftlers und eines männlichen Vorgesetzten, der sich vorbereitet und analysiert

RF2D6MEX7–Eine Mischung aus kleinen Biomolekülen und großen Makromolekülen (Proteinen). In der Biochemie des Lebens sind Tausende von verschiedenen Molekülen involviert.

RF3BR71D1–Das kreisförmige Life-Science-Gebäude Forskaren in Hagastaden in Stockholm, Schweden. Es wurde als Best Office Building 2024 und Stockholm Building of the ausgezeichnet

RF2E5EDB8–Brillen auf ein offenes Buch mit Protozoen Medizinische Parasitologie im Fokus mit anderen Life Science text Bücher im Hintergrund unscharf